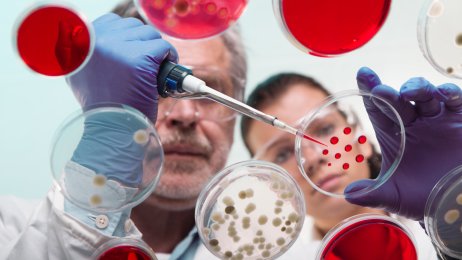
Legemidler Bildet viser to forskere i et laboratorium

Karita Bekkemellem
Administrerende direktørLegemiddelindustrien
Innlegg av Karita Bekkemellem som administrerende direktør:
– Nye legemidler er dyre av en grunn
– Vi kjenner oss ikke igjen i at treg innføring av nye legemidler bare handler om pris, skriver Karita Bekkemellem, administrerende direktør i Legemiddelindustrien.